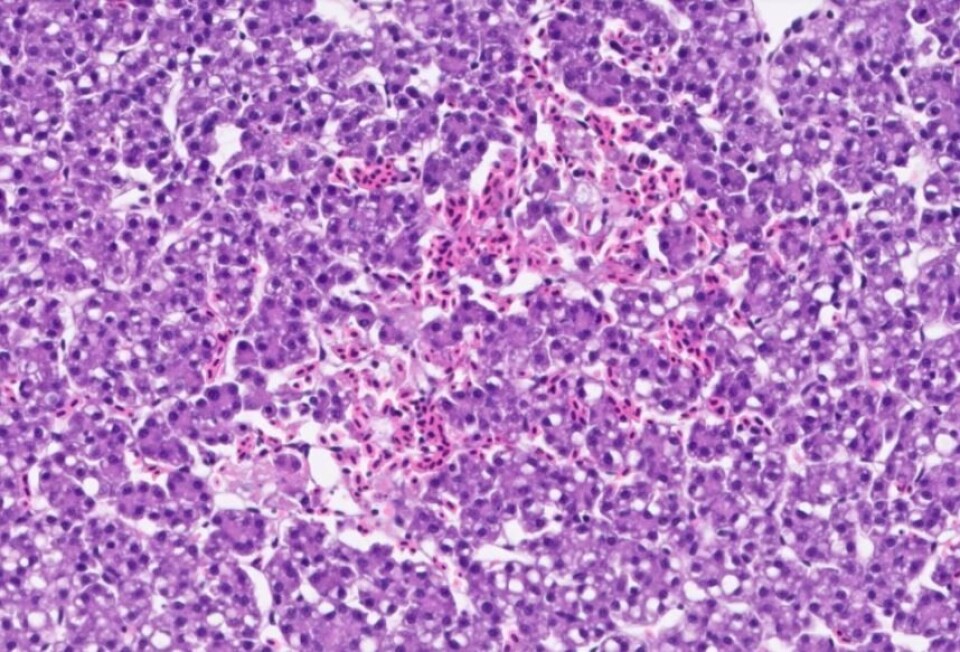

Algeoppblomstring mulig årsak til fiskedød
Høye sjøtemperaturer har ført til algeoppblomstring på vestlandet og histologiske resultater ligner på ILA.
Denne artikkelen er tre år eller eldre.
Pharmaq Analytiq fikk sist uke inn prøver fra flere ulike anlegg med laks, hvor histologiske prøver viste nekroser og blødninger i leveren. Ett av anleggene som har levert prøver er nå under ILA-mistanke, mens de andre er negative for ILA. Trolig dreier det seg om påvirkning fra algetoksiner, men andre årsaker ikke kan utelukkes, sier selskapet.
Ligner på ILA
Anleggene som er rammet melder om høy, men kort dødelighetstopp som nå er over. Histologisk likner tilstanden på ILA, hvor man kan se nekrose og blødninger i leveren. Det er derfor viktig å ta ut prøver slik at en eventuell mistanke raskt kan bekreftes eller avkreftes.
Histologisjef ved Pharmaq Analytiq, Renate Johansen har uttalt i en pressemelding at den varme sommeren gir økt risiko for algeoppblomstring, og det blir viktig å overvåke dette nøye fremover.

Toksinproduserende alger
Kyst.no har vært i kontakt med Kristine Braaten Steinhovden i SINTEF Ocean AS. Hun forteller at de har funnet Karenia i flere prøver fra det aktuelle området, men lave antall i forhold til faregrensen. Karenia er en gruppe alger som kan danne toksiner, og ved langvarig eksponering kan det resulterer i leverskade og fiskedød.
Hun sier at kundene i noen tilfeller har rapportert om brun farge i sjøen og dette er ofte en indikasjon på oppblomstring av Karenia.
- Karenia blomstrer i flak og kan dermed være vanskelig å påvise om du ikke treffer «rett på» et slikt flak ved uttak av vannprøver, forteller Braaten.
Hun forklarer videre at de også har funnet tilfeller av høye konsentrasjoner av det de mistenker er Karlodinium veneficum, og denne blomstrer gjerne sammen med Karenia.
- Basert på patologiske undersøkelser, funn i vannprøver, høyere vanntemperaturer i år enn foregående år og rapportering om brunt vann, kan vi gjøre en forsiktig antakelse om at Karenia kan ha vært en medvirkende årsak til at det har forekommet fiskedød på Sørvestlandet i sommer, avslutter hun.